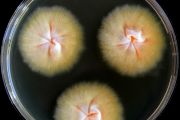
Patogen T. benhamiae var. luteum na agarové misce

Houby si při šíření kožní infekce z morčat na člověka mohou pomáhat toxiny
31. 10. 2025
Kožní infekce, které se šíří od domácích morčat na lidi, způsobuje houba Trichophyton benhamiae var. luteum. Nová studie týmu z Mikrobiologického ústavu Akademie věd ČR nyní odhaluje, proč je tak úspěšná – zřejmě si pomáhá tvorbou látek podobných toxinům.
Houbu Trichophyton benhamiae var. luteum popsali čeští vědci před několika lety jako původce epidemie, která zasáhla mnoho dětí napříč Evropou. Onemocnění, které přenášejí morčata na lidi, zejména na děti, se projevuje výraznou vyrážkou a zánětem kůže, nejčastěji na obličeji nebo rukách.
V nové studii se tým z Mikrobiologického ústavu AV ČR zaměřil na důvod snadného šíření této infekce. Prokázal, že houba zřejmě využívá toxické látky, které mohou oslabovat imunitní reakci hostitele, a tím usnadnit houbě přenos mezi morčaty, z morčete na člověka i mezi lidmi navzájem.
Trichophyton benhamiae var. luteum má sice blízké příbuzné v Evropě i v Americe, ti se však šíří mnohem pomaleji a jen výjimečně způsobují infekce. „Luteum“ varianta se tedy zdá evolučně výjimečně přizpůsobená k přenosu mezi morčetem a člověkem.
„Zjistili jsme, že právě geny spojené se sekundárními metabolity – tedy látkami, které houba vytváří mimo svou běžnou látkovou výměnu – jsou u tohoto kožního patogenu výrazně aktivnější,“ vysvětluje první autorka studie Lenka Machová z Mikrobiologického ústavu AV ČR (MBÚ AV ČR).
Kromě laboratorních experimentů tým využil i model kožní infekce na tkáních, který napodobuje reálné podmínky v myší kůži. „To nám umožnilo zjistit, jak houba reaguje ve svém přirozeném prostředí,“ doplňuje vedoucí výzkumného týmu Adéla Wennrich z MBÚ AV ČR.
Podle vedoucího Laboratoře genetiky a metabolismu hub v MBÚ AV ČR Miroslava Kolaříka jde o důležitý příspěvek k pochopení mechanismů, které umožňují některým druhům dermatofyt rychle se šířit a infikovat nové hostitele.
„Taková znalost je klíčová pro vývoj nových diagnostických nástrojů a léčebných strategií – a také pro ochranu veřejného zdraví,“ říká vědec.
Další výzkum se nyní zaměří na to, jaká je povaha některých z těchto toxických látek a jak přesně působí na lidské buňky. Lepší pochopení jejich mechanismu by v budoucnu mohlo umožnit cíleně zasahovat tento faktor virulence, tj. schopnost vyvolat nemoc, například při vývoji nových léčebných přístupů.
Kontakt:
Mgr. Adéla Wennrich, Ph.D.: adela.cmokova@biomed.cas.cz
Mgr. Lenka Machová: lenka.machova@biomed.cas.cz
Link na článek: https://journals.asm.org/doi/full/10.1128/spectrum.01383-25
Přečtěte si také
- Vědci objevili buněčný „bezpečnostní vypínač“, který chrání DNA před poškozením
- V pondělí startuje festival Týden Akademie věd ČR
- Akademie věd ocení excelentní vědce i výjimečné mladé talenty
- Průmyslová výroba nanodiamantů na dosah díky objevu z ÚOCHB AV ČR
- Otevřít archiv TGM 21. století. Vědci spojují síly s Českou spořitelnou
- Vznik života na Zemi a možná i jinde ve vesmíru zkoumá projekt PROTOCELL
- Může česká ekonomika vyrůst z dluhu?
- Věda pro praxi: ekologický plovoucí čistič vody hledá partnery pro testování
- Vědci odhalili buňky, které pohánějí zánět u roztroušené sklerózy
- Zarůstání středomořské krajiny ohrožuje unikátní noční motýly
Chemické vědy
Vědecká pracoviště
- Ústav analytické chemie AV ČR
Ústav anorganické chemie AV ČR
Ústav chemických procesů AV ČR
Ústav fyzikální chemie J. Heyrovského AV ČR
Ústav makromolekulární chemie AV ČR
Ústav organické chemie a biochemie AV ČR
Chemický výzkum navazuje na tradici vytvořenou významnými českými chemiky jako Rudolfem Brdičkou, Jaroslavem Heyrovským, Františkem Šormem či Ottou Wichterlem. V teoretické i experimentální fyzikální chemii je výzkum orientován na vybrané úseky chemické fyziky, elektrochemie a katalýzy. Anorganický výzkum je zaměřen na přípravu a charakterizaci nových sloučenin a materiálů. Výzkum v oblasti organické chemie a biochemie se soustřeďuje zejména na medicínu a biologii s cílem vytvořit nová potenciální léčiva a dále do ekologie. V oblasti makromolekulární chemie jde o přípravu a charakterizaci nových polymerů a polymerních materiálů, které lze využít v technice, v biomedicíně a ve výrobních, zejména separačních, technologiích. Analytická chemie rozvíjí separační analytické techniky, zejména kapilární mikrometod, a dále se zaměřuje na metody spektrální. Chemicko-inženýrský výzkum je orientován na vícefázové systémy, homo- a heterogenní katalýzu, termodynamiku a moderní separační metody. Sekce zahrnuje 6 ústavů s přibližně 1270 zaměstnanci, z nichž je asi 540 vědeckých pracovníků s vysokoškolským vzděláním.